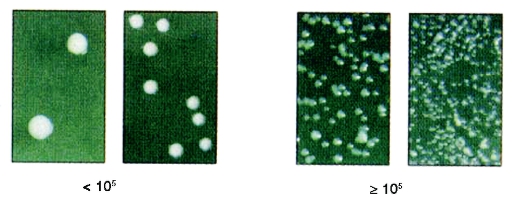

Терапевтическая стоматология. Болезни зубов: учебник: в 3 ч. / под ред. Е.А. Волкова, О.О. Янушевича. - 2013. - Ч. 1. - 168 с. : ил.
|
|
|
|
Глава 2. КАРИЕС ЗУБОВ
Кариес зубов (рис. 2.1) до настоящего времени остается актуальной проблемой в стоматологии. Это заболевание возникает после прорезывания зубов. В основе его лежит процесс деминерализации и протеолиза твердых тканей зубов, приводящий к образованию дефекта в виде полости.

Рис. 2.1. Кариес зубов
2.1. КРИТЕРИИ ОЦЕНКИ КАРИОЗНЫХ ПОРАЖЕНИЙ
Критериями для оценки состояния твердых тканей зубов в популяции являются распространенность и интенсивность кариеса временных и постоянных зубов.
Распространенность кариеса зубов - это отношение количества лиц, имеющих хотя бы один из признаков проявления кариеса зубов (кариозные, пломбированные или удаленные зубы), к общему количеству обследованных, выраженное в процентах.
Оценочные критерии ВОЗ распространенности кариеса зубов у 12-летних детей.
Уровень распространенности кариеса зубов у 12-летних (критерии ВОЗ): низкий 0-30%; средний 31-80%; высокий 81-100%.
Интенсивность кариеса зубов - это сумма клинических признаков кариозного поражения (кариозные, пломбированные и удаленные зубы), рассчитанная индивидуально для одного пациента или группы обследованных.
Для оценки интенсивности кариеса временных зубов используют индексы:
• кпу (з) - сумма пораженных кариесом, пломбированных и удаленных зубов у одного обследованного ребенка;
• кпу (п) - сумма поверхностей зубов, пораженных кариесом, пломбированных и удаленных у одного обследованного ребенка.
Примечание. При определении количества удаленных зубов или поверхностей считают лишь те, которые удалены преждевременно, до физиологического рассасывания корней.
Для оценки интенсивности кариеса постоянных зубов используют индексы:
• КПУ (з) - сумма пораженных кариесом, пломбированных и удаленных по поводу осложнений кариеса зубов у одного обследованного;
• КПУ (п) - сумма поверхностей зубов, пораженных кариесом, пломбированных и удаленных по поводу осложнений кариеса у одного обследованного.
Примечание. Если удален зуб передней группы, то при расчете индекса КПУ (п) учитывают 4 поверхности, если удален зуб жевательной группы - 5 поверхностей. При определении индексов интенсивности кариеса не учитывают его начальную форму в виде очаговой деминерализации эмали.
Для оценки интенсивности кариеса в период смены зубов (с 6 до 12 лет) используют индексы КПУ и кп зубов и поверхностей. Интенсивность кариеса временных и постоянных зубов и поверхностей рассчитывают отдельно.
Интенсивность кариеса в группе обследованных - это отношение суммы индивидуальных показателей индексов интенсивности кариеса зубов или поверхностей к количеству обследованных.
Уровень интенсивности кариеса зубов (по индексу КПУ) у 12-летних детей и взрослых (критерии ВОЗ):
2.2. РАСПРОСТРАНЕННОСТЬ И ИНТЕНСИВНОСТЬ КАРИЕСА ЗУБОВ СРЕДИ НАСЕЛЕНИЯ РОССИИ
В настоящее время кариес зубов - одно из наиболее распространенных стоматологических заболеваний среди детского и взрослого населения Российской Федерации.
По данным эпидемиологического стоматологического обследования (2009), проведенного среди ключевых возрастных групп населения России, распространенность кариеса временных зубов у 6-летних детей составила 84%, средняя интенсивность кариеса временных зубов по индексу кпу (з) - 4,83, при этом компонент «к» равен 2,9, «п» - 1,55, «у» - 0,38.
Средние показатели распространенности и интенсивности кариеса постоянных зубов у населения России:
Приведенные данные - результат национального эпидемиологического стоматологического обследования 55 391 человека, проживающих в 47 регионах РФ. Обследование проведено в 20072008 гг. с использованием кодов и критериев оценки стоматологического статуса, предложенных ВОЗ.
Согласно полученным результатам, заболеваемость кариесом в различных районах неодинаковая. Наиболее существенная взаимосвязь выявлена между интенсивностью кариеса временных и постоянных зубов и содержанием фторидов в питьевой воде: при концентрации фторидов более 0,7 мг/л она ниже и увеличивается, если содержание фторидов менее 0,7 мг/л. Более четко эта зависимость прослеживается в возрастных группах 6, 12 и 15 лет. Среди взрослого населения подобная тенденция выражена в меньшей степени, что, вероятно, обусловлено действием множества кариесогенных факторов (рис. 2.2, 2.3).

Рис. 2.2. Средняя интенсивность кариеса временных зубов в районах с различным содержанием фторидов в питьевой воде

Рис. 2.3. Средняя интенсивность кариеса постоянных зубов в районах с различным содержанием фторидов в питьевой воде
Средние показатели интенсивности кариеса у городского и сельского населения существенно не различались.
Низкий уровень интенсивности кариеса по градации ВОЗ у 12-летних зарегистрирован в 27 регионах, средний - в 19, а высокий - в одном регионе.
Уровень интенсивности кариеса зубов у взрослого населения в большинстве регионов оценивали по градации ВОЗ как высокий.
При анализе результатов второго национального эпидемиологического стоматологического обследования выявлена тенденция к снижению средних показателей интенсивности кариеса постоянных зубов у детского населения по сравнению с данными 10-летней давности (1999), однако у взрослых и лиц пожилого возраста они по-прежнему остаются высокими.
2.3. ПОТРЕБНОСТЬ В ЛЕЧЕНИИ ЗУБОВ
НАСЕЛЕНИЯ РОССИИ
Результаты обследования населения позволили определить потребность в различных видах лечения твердых тканей зубов. Так, 52% шестилетних детей требуется пломбирование одной поверхности, а 45% - двух и более поверхностей временных зубов. В эндодонтическом лечении и удалении зубов нуждаются 13 и 22% соответственно.
Потребность в лечении постоянных зубов в данной возрастной группе сводилась в основном к необходимости профилактических мероприятий, в частности герметизации фиссур первых постоянных моляров (52%), назначении реминерализующей терапии (51%), а также пломбировании одной (13%) и двух (5%) поверхностей постоянных зубов.
В группе 12-летних резко возрастает потребность в пломбировании зубов (46% - одной, 21% - двух поверхностей и более), эндодонтическом лечении и удалении постоянных зубов (8 и 10% соответственно), а потребность в проведении профилактических мероприятий (герметизации фиссур вторых постоянных моляров) остается высокой (48%).
У 15-летних подростков увеличивается потребность в перечисленных видах стоматологической помощи, определяется нуждаемость в ортопедическом лечении - изготовлении искусственных коронок.
У взрослого населения сохраняется высокая потребность в пломбировании, протезировании (55%) и удалении (23%) зубов, а лица пожилого возраста в основном нуждались в протезировании (63%) и удалении зубов (35%).
2.4. ФАКТОРЫ РИСКА ВОЗНИКНОВЕНИЯ КАРИЕСА ЗУБОВ
Местные факторы:
• наличие зубного налета (неудовлетворительный гигиенический уход за полостью рта);
• высокое содержание легкоферментируемых углеводов в рационе питания;
• изменение количественного и качественного состава ротовой жидкости;
• низкая кариесрезистентность эмали;
• незавершенная минерализация эмали фиссур постоянных зубов в период их прорезывания;
• наличие факторов, способствующих ретенции зубного налета (аномалии положения зубов, несъемные ортодонтические и ортопедические конструкции, нависающие края пломб и т.д.).
Общие факторы:
• низкое содержание фторидов в питьевой воде;
• несбалансированное питание, алиментарный дефицит минеральных веществ (прежде всего, кальция и фосфатов), витаминов;
• соматические заболевания (хроническая патология пищеварительного тракта, эндокринной системы), нарушение обмена веществ, гиповитаминозы; врожденные аномалии челюстно-лицевой области;
• экстремальные воздействия на организм, стресс;
• неблагоприятная экологическая обстановка. В большей степени риску возникновения кариеса подвержены следующие группы:
• беременные и дети раннего возраста (от 0 до 3 лет);
• дети в период прорезывания постоянных зубов;
• лица, у которых затруднен гигиенический уход за полостью рта (имеющие несъемные ортодонтические и ортопедические конструкции, аномалии положения зубов и т.д.);
• рабочие вредных производств (химических, кондитерских и др.).
2.4.1. МЕТОДЫ ОПРЕДЕЛЕНИЯ РИСКА ВОЗНИКНОВЕНИЯ КАРИЕСА ЗУБОВ
ОЦЕНКА ГИГИЕНИЧЕСКОГО СОСТОЯНИЯ
ПОЛОСТИ РТА
Зубной налет обнаруживают визуально при осмотре полости рта с помощью стоматологического зонда и при использовании индикаторных средств:
1) таблеток, растворов, содержащих эритрозин, фуксин (таблетки «Espo-Plak» («Paro»), «RedCote» («Butler»), раствора для индикации зубного налета («PresiDENT») и др.;
2) йодсодержащих растворов (растворов Люголя, Шиллера-Писарева) (рис. 2.4);
3) препаратов, содержащих флюоресцин, для визуализации зубного налета в ультрафиолетовых лучах.

Рис. 2.4. Зубной налет, окрашенный раствором Шиллера-Писарева
ИНДЕКСЫ ДЛЯ ОПРЕДЕЛЕНИЯ ГИГИЕНИЧЕСКОГО СОСТОЯНИЯ ПОЛОСТИ РТА
1. Индекс оценки зубного налета у детей раннего возраста (с момента прорезывания первых зубов до 3 лет) (Кузьмина Э.М., 2000).
Для оценки данного индекса визуально или с помощью стоматологического зонда определяют наличие зубного налета на всех зубах, имеющихся в полости рта.
Коды и критерии оценки:
0 - налет отсутствует;
1 - наличие зубного налета. Расчет индекса:

где ИГ - индекс гигиены у детей раннего возраста. Интерпретация результатов
2. Индекс Федорова-Володкиной (1971).
Рекомендован для оценки гигиенического состояния полости рта у детей в возрасте до 5-6 лет. Для оценки индекса проводят окрашивание вестибулярной поверхности шести фронтальных зубов нижней челюсти: 83, 82, 81, 71, 72, 73.
Коды и критерии оценки:
1 - отсутствие окрашивания;
2 - окрашивание 1/4 поверхности коронки зуба;
3 - окрашивание 1/2 поверхности коронки зуба;
4 - окрашивание 3/4 поверхности коронки зуба;
5 - окрашивание всей поверхности коронки зуба. Расчет индекса

где ИГ - индекс гигиены Федорова-Володкиной.
Интерпретация результатов
3. Индекс эффективности гигиены полости
рта РНР (Podshadley A.G., Haley P., 1968). Индексные зубы:
16, 11, 26, 31 - вестибулярная поверхность;
36, 46 - оральная поверхность.
При отсутствии индексного зуба проводят окрашивание соседнего зуба в пределах одноименной группы.
Обследуемую поверхность зуба делят на 5 участков:

1 - медиальный; 2 - дистальный;
3 - срединно-окклюзионный;
4 - центральный; 5 - срединнопришеечный.
Коды и критерии оценки:
0 - отсутствие окрашивания;
1 - окрашивание любой интенсивности. Расчет индекса:

где РНР - индекс эффективности гигиены полости рта.
Интерпретация результатов
4. Индекс гигиены полости рта ИГР-У
(OHI-S - Oral Hygiene Index-Simplified; Greene J.S., Vermillion J.K., 1964).
Определяет наличие зубного налета (с помощью окрашивания поверхностей индексных зубов индикаторными растворами) и зубного камня (методом зондирования).
Индексные зубы:
16, 11, 26, 31 - вестибулярная поверхность; 36, 46 - оральная поверхность. Коды и критерии оценки зубного налета: 0 - зубной налет не выявлен;
1 - мягкий зубной налет, покрывающий не более 1/3 поверхности зуба, или наличие любого количества пигментированного зубного налета;
2 - мягкий зубной налет, покрывающий более 1/3, но менее 2/3 поверхности зуба;
3 - мягкий зубной налет, покрывающий более 2/3 поверхности зуба.
Коды и критерии оценки зубного камня:
0 - зубной камень не выявлен;
1 - наддесневой зубной камень, покрывающий не более 1/3 поверхности зуба;
2 - наддесневой зубной камень, покрывающий более 1/3, но менее 2/3 поверхности зуба, или наличие отдельных отложений поддесневого камня в пришеечной области зуба;
3 - наддесневой зубной камень, покрывающий более 2/3 поверхности зуба, или наличие значительных отложений поддесневого камня вокруг пришеечной области зуба.
Расчет индекса:

где ИГР-У - упрощенный индекс гигиены полости рта.
Интерпретация результатов
5. Индекс налета на апроксимальных поверхностях зубов API (Lange D.E., Plagmann H.,
1977).
С помощью окрашивания определяют наличие зубного налета на контактных поверхностях зубов и в межзубных промежутках:

II и IV квадранты - с вестибулярной поверхности; I и III квадранты - с оральной поверхности.
Критерии оценки:
0 - налет отсутствует;
1 - наличие налета в межзубном промежутке. Расчет индекса:

где API - индекс налета на апроксимальных поверхностях зубов.
Интерпретация результатов
2.5. ОЦЕНКА СВОЙСТВ РОТОВОЙ ЖИДКОСТИ И ЗУБНОГО НАЛЕТА
Определение скорости секреции слюны.
Сбор слюны рекомендуется проводить через 1,52 ч после приема пищи. Пациента заранее предупреждают, что в течение этого времени следует воздержаться от употребления жевательной резинки, конфет, курения, обильного питья, полоскания рта.
Для определения скорости нестимулированного слюноотделения пациент в состоянии покоя в течение 5 мин сплевывает в пробирку с воронкой имеющуюся в полости рта слюну. Скорость выделения стимулированной слюны определяют путем сбора в пробирку слюны, выделяющейся при жевании парафинового шарика.
В обоих случаях фиксируют объем собранной слюны и определяют скорость слюноотделения (мл/мин).
Норма:
• скорость нестимулированного слюноотделения - 0,2-0,5 мл/мин;
• при механической стимуляции - 1-3 мл/мин.
Определение вязкости слюны. Тест проводят с помощью вискозиметра Освальда натощак или через 3 ч после приема пищи. Измерения осуществляют троекратно.
Норма - 4,16 ЕД; увеличение вязкости слюны в 2 раза и более свидетельствует о низкой кариесрезистентности эмали.
Экспресс-метод диагностики буферных свойств слюны с помощью системы «CRT buffer».
Система включает тестовую индикаторную полоску и контрольную градационную шкалу. Каплю стимулированной слюны наносят стерильной пипеткой на подушечку тестовой полоски. Через 5 мин оценивают результат путем сравнения цвета полоски с цветовой таблицей (рис. 2.5).
Цвет индикаторной полоски:
• синий (рН >6,0) - высокая (нормальная) буферная емкость;
• зеленый (рН=4,5-5,5) - средняя (ниже нормы) буферная емкость;
• желтый (рН <4,0) - низкая буферная емкость слюны.
Примечание. Если окрашивание получилось неоднородным, интерпретируют результат в сторону более низкого значения.

Рис. 2.5. Определение буферной емкости слюны с помощью системы «CRT buffer»
рН-метрия ротовой жидкости и зубного налета. Точное определение рН ротовой жидкости и зубного налета проводят с помощью рНселективного электрода. Смешанную слюну собирают натощак утром в количестве 20 мл. После
троекратного исследования одного и того же образца рассчитывают средний показатель. Измерить рН ротовой жидкости можно непосредственно в полости рта пациента, поместив электрод в подъязычную область (норма в состоянии покоя - 6,8-7,4; при рН менее 6,0 слюна способствует процессу деминерализации эмали).
Для определения рН зубного налета зуб изолируют от слюны с помощью ватных валиков и высушивают воздухом. Электрод помещают последовательно на вестибулярную и оральную поверхности зубов в пришеечной области и фиксируют показания прибора (норма в состоянии покоя 6,5-6,7, критическое значение рН зубного налета, при котором начинается процесс деминерализации эмали, - 5,5-5,7).
Экспресс-метод определения количества кариесогенных бактерий (S. mutans и Lactobacilli) с помощью системы «CRT bacteria». Для исследования собирают стимулированную слюну или образцы зубного налета и проводят посев на пластину с агаровым покрытием (представляет собой селективную питательную среду для S. mutans или Lactobacilli), которую инкубируют в течение 48 ч при температуре 37 °С.
Сравнивают плотность колоний, выросших на агаровых поверхностях, со значением плотности в эталонной таблице. Плотность колоний S. mutans и Lactobacilli более 105 КОЕ/мл свидетельствует о высокой степени риска возникновения кариеса зубов, менее 105 КОЕ/мл - о низкой (рис. 2.6).
Примечание. Перед обследованием пациенты не должны пользоваться антибактериальными ополаскивателями, не рекомендуется проведение профессиональной гигиены полости рта.
Несмотря на очевидные успехи в профилактике кариеса зубов, эта болезнь все еще представляет серьезную проблему для здравоохранения в большинстве стран мира, особенно в связи с неуклонным ростом стоимости восстановительного лечения и новыми доказательствами взаимосвязей осложнений кариеса и ряда общесоматических заболеваний.
Рис. 2.6. Варианты плотности колоний Lactobacilli, определяемой с помощью системы «CRT bacteria»
Для удобства обозначения зубов в зубной дуге и записи результата осмотра зубов используют различные схемы.
Длительное время в нашей стране пользовались схемой Зигмонда-Палмера, предложенной в 1876 г. По этой схеме в каждом квадранте зубы пронумерованы от 1 до 8, т.е. от центральных резцов до зубов мудрости. Для обозначения постоянных зубов используют арабские цифры, для молочных - римские. Принадлежность зуба к верхней или нижней челюсти и стороне расположения определяется направлением пересечения горизонтальных и вертикальных линий, разделяющих квадранты (рис. 2.7).
В настоящее время целесообразно применять цифровые системы, которые являются более удобными. В мире широко используется система Международной федерации стоматологов (FDI). Эту систему рекомендуют Всемирная организация здравоохранения (ВОЗ) и Международная организация стандартизации (ISO). В этой системе каждый постоянный зуб в каждом квадранте обозначают цифрой от 1 до 8, как и в системе Зигмонда-Палмера. Временные зубы также обозначают цифрами от 1 до 5. Квадранты пронумерованы по часовой стрел-
ке, начиная с верхнего правого квадранта. В постоянном прикусе квадранты нумеруют от 1 до 4, в молочном - от 5 до 8. Таким образом, каждый зуб обозначают двумя цифрами: первая цифра - номер квадранта, вторая - номер зуба в квадранте. Так, например, второй левый премоляр верхней челюсти будет обозначаться как зуб 24, а левый верхний латеральный временный резец - 62 (рис. 2.8).
2.6. ТЕОРИИ КАРИЕСА ЗУБОВ
До формирования современного взгляда на происхождение кариеса зубов было предложено значительное количество теорий возникновения этого заболевания. Большое влияние на развитие кариесологии оказала предложенная в конце XIX в. химико-паразитарная теория кариеса Миллера, базирующаяся на имеющихся в то время клинических и экспериментальных данных. В ней он окончательно сформулировал свой взгляд на кариес на основе проведенных in vitro исследований. Суть их заключалась в том, что удаленные зубы человека помещали в смесь слюны, хлеба, мяса и 2-4% раствора сахара и выдерживали в термостате при тем-

Рис. 2.7. Система Зигмонда-Палмера

Рис. 2.8. Система FDI
пературе 37 °С в течение 4-6 нед. Под воздействием продуктов молочно-кислого брожения происходила деминерализация эмали, в какой-то степени сходная с изменениями в ней при кариесе.
Это позволило предположить, что разрушение твердых тканей зуба при кариесе представляет собой химико-паразитарный процесс, состоящий из двух фаз. В первой фазе происходит деминерализация минерального компонента эмали и дентина под воздействием органических кислот, образуемых в результате молочно-кислого брожения углеводов пищи. Во второй фазе под влиянием протеолитических ферментов микроорганизмов происходит разрушение органического вещества зуба.
В 1928 г. Д.А. Энтин разработал физикохимическую теорию кариеса, согласно которой твердые ткани зуба представляют собой полупроницаемую мембрану на границе двух сред - ротовой жидкости (слюны) и пульпы зуба (крови). Ученый считал, что преобладание осмотических токов в центростремительном направлении вызывает патологические изменения в твердых тканях зубов, так как нарушается питание эмали со стороны пульпы и усиливается воздействие на эмаль внешних агентов, в частности микроорганизмов, что приводит к кариесу.
Известны другие теории: нервно-трофическая теория Д.А. Энтина (1928), биологическая теория кариеса И.Г. Лукомского (1948), обменная теория А.Э. Шарпенака (1949), рабочая концепция патогенеза кариеса зубов А.И. Рыбакова (1971).
Установлено, что кариес зубов - инфекционный процесс, проявляющийся после прорезывания зубов, при котором происходят деминерализация и протеолиз твердых тканей зуба с последующим образованием дефекта в виде полости.
Главной причиной деминерализации эмали и образования кариозного очага являются органи-
ческие кислоты. Основную роль играет молочная кислота. Кислоты образуются в процессе ферментации углеводов, поступающих с пищей, микроорганизмами зубного налета.
Избыточное употребление углеводов и недостаточный гигиенический уход за полостью рта приводят к тому, что на поверхности зуба аккумулируются и размножаются кариесогенные микроорганизмы и формируется зубной налет. Продолжающееся потребление углеводов способствует локальному изменению рН в нем в кислую сторону. В клиникоэкспериментальных исследованиях это убедительно демонстрируется кривой Стефана, которая отражает динамику изменения рН зубного налета при поступлении в него моносахаридов, например глюкозы (рис. 2.9).
Вначале происходит резкое снижение рН зубного налета - до 4,5, а затем показатель медленно в течение 30-40 мин восстанавливается до нормы. Если в дальнейшем снижение рН постоянно повторяется, то в результате деминерализации формируются подповерхностные очаги поражения (кариозное пятно), а в последующем и кариозные полости. Существенное значение при этом имеет состояние структуры твердых тканей зуба.
Устойчивость (кариесрезистентность) зубов к кариесу формируется при полноценных химическом составе, структуре, проницаемости эмали и других тканей зуба. Немаловажное значение имеют количество ротовой жидкости (слюны) и ее минерализующий потенциал. Сбалансированная в отношении углеводов диета, хорошая гигиена полости рта и оптимальное содержание фтора в питьевой воде также являются составляющими устойчивости зубов к кариесу.
При нарушениях, возникающих в процессе развития тканей зубов, созревания эмали при изменении параметров ротовой жидкости, недостаточном

Рис. 2.9. Кривая Стефана
содержании фтора в питьевой воде, избытке углеводов в пище, плохой гигиене полости рта, патологии органов и систем организма, возможно снижение устойчивости к кариесу (кариесвосприимчивость).
2.7. РОЛЬ ЗУБНОГО НАЛЕТА, СЛЮНЫ И ПРОНИЦАЕМОСТИ ЭМАЛИ ПРИ КАРИЕСЕ
Известно, что на эмали определяется ряд поверхностных образований. Кутикула, представляющая собой редуцированный эпителий эмалевого органа, вскоре после прорезывания зуба в результате истирания при жевании исчезает и частично остается только в подповерхностном слое эмали.
Поверхность функционирующего зуба в дальнейшем покрывается пелликулой (приобретенной кутикулой), которая представляет собой белковоуглеводный комплекс, формируемый под воздействием слюны. Пелликула прочно соединена с поверхностью эмали за счет внедрения в ее поверхностный слой.
Следующим поверхностным образованием является формируемый на пелликуле зубной налет, представляющий собой мягкие отложения на поверхности эмали. Для обозначения этой субстанции применяют такие термины, как «зубная бляшка», «биопленка».
Чаще всего зубной налет выступает как мощный кариесогенный фактор, что обусловливает необходимость тщательного и регулярного его удаления.
Важный этап формирования зубного налета - инкорпорация различных типов микроорганизмов в его матрицу. Взаимоотношения этих микроорганизмов между собой и организмом в целом обеспечивают определенный микробный гомеостаз в зубном налете, при котором зубы и ткани пародонта остаются интактными. Нарушение имеющегося баланса под воздействием неблагоприятных внутренних и внешних факторов приводит к развитию патологии, например кариеса.
Среди значительного разнообразия видов микроорганизмов зубного налета в качестве потенциально кариесогенных рассматривают кислотообразующие микроорганизмы. По современным представлениям, к наиболее вероятным инфекционным агентам кариозного процесса относят кислотообразующие штаммы St. mutans и Lactobacilli. Предполагают, что St. mutans инициирует начало деминерализации эмали при кариесе. Лактобациллы включаются в процесс позднее и активны при кариесе в стадии дефекта.
Образование, состав, свойства и функции зубного налета тесно связаны с состоянием полости рта и организма в целом. Считают, что кариесогенный
потенциал зубного налета может реализоваться только при таких общих и местных факторах риска, как, например, избыточное потребление сахара с пищей, недостаток фтора в питьевой воде, плохая гигиена полости рта и др.
Состав и свойства зубного налета находятся в тесной взаимосвязи со слюной. Восприимчивость или устойчивость зубов к кариесу определяют такие параметры слюны, как скорость секреции, буферная емкость, концентрация водородных ионов (рН), бактерицидность, содержание минеральных и органических компонентов.
В процессе омывания зубов слюной осуществляется клиренс веществ в зубном налете и тканях зуба. Между слюной и эмалью зуба происходит обмен ионами кальция и фосфата, в результате чего устанавливается равновесие их в поверхностном слое эмали, зубном налете и слюне. Этому способствует перенасыщенность слюны ионами кальция и фосфора.
Важную роль в защите зубов от кариеса играет буферная емкость слюны, обеспечивающая нейтрализацию кислот и щелочей. Основу буферной способности слюны составляют карбонаты, фосфаты и белки.
Концентрация водородных ионов в слюне находится в нейтральном диапазоне. В зубном налете рН при отсутствии кариесогенной ситуации практически равен рН слюны и в значительной степени контролируется буферной системой слюны.
Кроме того, за счет буферной способности слюны возможны реминерализация подповерхностного очага поражения при кариесе и приостановка дальнейшей деминерализации.
Защитная функция слюны. Слюна обладает минерализующими свойствами. Самым прямым доказательством этого факта является развитие «цветущего» кариеса вслед за прекращением функционирования слюнных желез в результате облучения большими дозами при опухолях головы и шеи. Такой кариес настолько разрушителен, что в течение нескольких недель поражает обычно кариесрезистентные поверхности зубов и вызывает полную деструкцию зубов.
Основные свойства слюны, реализующие защиту от кариеса:
• разведение и клиренс сахаров, поступающих в полость рта с пищей;
• нейтрализация кислот в зубном налете;
• источник ионов для реминерализации твердых тканей зубов.
Зубы человека не растворяются в слюне потому, что она перенасыщена ионами кальция, фосфата и гидроксила. Из этих же ионов состоит в основном минеральная фракция зубов. В динамическом равновесии процесса обмена перенасыщение слюны ионами кальция и фосфата обеспечивает защиту
от деминерализации. Перенасыщенное состояние слюны преодолевается только тогда, когда рН зубного налета достаточно низкий, чтобы концентрация ионов гидроксила и фосфата стала ниже критического значения.
Проницаемость эмали. Одним из немногих физиологических свойств, доступных исследованию, является проницаемость твердых тканей зубов и особенно эмали.
Проницаемость эмали зависит от многих факторов и условий. Имеются данные, что некоторые ионы могут проникать внутрь кристаллов и участвовать во внутрикристаллическом обмене. Например, фтор вытесняет гидроксильный ион в поверхностном слое кристаллов гидроксиапатита эмали, таким образом увеличивая ее кислотоустойчивость.
Большое влияние на скорость и глубину проникновения веществ в эмаль оказывает степень минерализации твердых тканей, повышающаяся с возрастом. Кроме того, уровень проницаемости эмали может изменяться под воздействием физических и химических факторов. Скорость и глубина проникновения веществ в эмаль зависят от характера проникающего вещества, времени его контакта с зубом. Ион фтора проникает в эмаль не более чем на 15-80 мкм.
2.8. КЛАССИФИКАЦИЯ КАРИЕСА ЗУБОВ
В отечественной стоматологии наиболее широко использовали топографическую классификацию кариеса.
1. Начальный кариес, или кариес в стадии пятна.
2. Поверхностный кариес.
3. Средний кариес.
4. Глубокий кариес.
Рациональная систематизация кариеса дана в рекомендованной ВОЗ Международной классификации стоматологических болезней МКБ-С-3, созданной на основе МКБ-10, согласно которой кариес (код К02) классифицируется следующим образом:
К02.0. Кариес эмали. Стадия белого (меловидного) пятна (начального кариеса). К02.1. Кариес дентина. К02.2. Кариес цемента. К02.3. Приостановившийся кариес зубов. К02.4. Одонтоклазия. Детская меланодентия. Меланодонтоклазия.
Из этого раздела исключена внутренняя и внешняя патологическая резорбция зубов (К03.3). К02.8. Другой уточненный кариес зубов. К02.9. Кариес зубов неуточненный. В МКБ-С-3 отсутствует диагноз «глубокий кариес». В настоящее время в связи с переходом клинической стоматологии на классификацию МКБ исключение диагноза «глубокий кариес» оправданно, поскольку клиническая картина и лечение глубокого кариеса укладываются в рамки МКБ-С-3 и позволяют отнести глубокий кариес к разделу болезней пульпы зубов и рассматривать его как начальный пульпит или гиперемию пульпы соответственно коду К04.00.
Классификация кариеса зубов, предложенная Е.В. Боровским и П.А. Леусом (1979), включает клинические формы болезни с учетом глубины поражения, локализации, течения и интенсивности поражения.
КЛАССИФИКАЦИЯ КАРИЕСА ЗУБОВ БОРОВСКОГО-ЛЕУСА
2.9. ПАТОЛОГИЧЕСКАЯ АНАТОМИЯ КАРИЕСА ЗУБОВ
При кариесе в стадии пятна в эмали выявляется очаг поражения в виде треугольника, основание которого обращено к наружной поверхности, а верхушка направлена в сторону эмалево-дентинной границы.
При поляризационной микроскопии в зависимости от обширности очага поражения в эмали определяются от трех до пяти зон с различной степенью деминерализации (рис. 2.10).

Рис. 2.10. Схематическое изображение зон деминерализации при кариесе в стадии пятна (поляризационная микроскопия): 1 - поверхностный (интактный) слой; 2 - тело поражения; 3 - темная зона; 4 - прозрачная зона
• Зона 1 - поверхностный слой шириной до 50 мкм относительно интактной эмали.
• Зона 2 - центральная зона (тело поражения), в которой деминерализация выражена еще больше, объем микропространств увеличивается до 25%. Очень высокая степень проницаемости эмали.
• Зона 3 - темная зона, в которой объем микропространств лежит в пределах 15-17%.
• Зона 4 - внутренний слой, или прозрачная зона, объем микропространств составляет
0,75-1,5%.
Кариес дентина. Начинается кариес дентина с разрушения области эмалево-дентинного соединения и распространяется вдоль дентинных канальцев по направлению к пульпе. В дентине и пульпе происходят защитные процессы. Дентинные канальцы склерозируются, а отростки одонтобластов оттес-
няются в центральном направлении. В результате защитной реакции на границе дентина и пульпы происходит образование заместительного, или иррегулярного, дентина, который отличается от нормального менее ориентированным расположением дентинных канальцев.
При кариесе происходит нарушение структурной целостности дентина вследствие деминерализации его минеральной составляющей, дезинтеграции и растворения органической матрицы. В очаге кариозного поражения дентина выделяют 5 зон
(рис. 2.11).

Рис. 2.11. Зоны поражения в дентине при кариесе зубов: 1 - интактный дентин; 2 - полупрозрачный дентин; 3 - прозрачный дентин; 4 - мутный дентин; 5 - инфицированный дентин
• Зона 1 - нормальный дентин. В этой зоне строение дентинных трубочек не изменено, отростки одонтобластов заполняют дентинные трубочки.
• Зона 2 - полупрозрачный дентин. Слой полупрозрачного дентина образуется в результате деминерализации дентина между дентинными трубочками. Кроме этого наблюдается отложение минеральных веществ внутри дентинных трубочек. В этой зоне микроорганизмы не определяются.
• Зона 3 - прозрачный дентин. Степень деминерализации этой зоны более выраженна. Клинически это проявляется размягчением дентина. Однако часть коллагеновых волокон остается неповрежденной, что может обеспечить возможность реминерализации этой зоны при благоприятных условиях. Микроорганизмы в этой зоне отсутствуют.
• Зона 4 - мутный дентин. В этой зоне определяется расширение дентинных канальцев. Вследствие значительной дезинтеграции коллагеновых волокон реминерализация этой зоны дентина практически невозможна. В этой зоне всегда присутствуют микрорганизмы в расширенных дентинных канальцах. Клинически дентин размягчен и, как правило, подлежит удалению.
• Зона 5 - инфицированный дентин. Зона распада всех структур дентина, насыщенная микроорганизмами. Эта зона при лечении должна быть полностью удалена. При кариесе могут происходить изменения и в пульпе. Степень выраженности этих изменений зависит от течения и глубины поражения. При кариесе в стадии белого пятна и при поверхностном кариесе изменений в пульпе, как правило, нет. Если кариозный процесс распространяется на дентин, в пульпе обнаруживают выраженные морфологические изменения сосудов и нервных волокон. Наблюдаются дезориентация и уменьшение количества одонтобластов. Раздражение одонтобластов приводит к образованию заместительного дентина.
2.10. ДИАГНОСТИКА, КЛИНИЧЕСКАЯ КАРТИНА, ДИФФЕРЕНЦИАЛЬНАЯ ДИАГНОСТИКА КАРИЕСА ЗУБОВ
2.10.1. МЕТОДЫ ДИАГНОСТИКИ КАРИЕСА ЗУБОВ
При начальном кариесе, преимущественно в стадии белого пятна, целесообразно визуальное обследование доступных поверхностей зуба. Обычно для этого зубы очищают от зубного налета и высушивают струей воздуха. В результате этой процедуры зоны, где имеются подповерхностные дефекты в виде белых или в меньшей степени пигментированных пятен, отличаются по окраске от здоровой эмали.
Высокая проницаемость эмали при начальных поражениях позволяет установить локализацию и в какой-то мере степень деминерализации при кариесе в стадии пятна путем витального окрашивания тканей зуба. Для такого исследования необходимо поверхность зуба очистить от зубного налета, изолировать от слюны и высушить. Окрашивают обычно 2% раствором метиленового синего. Интенсивность окраски пораженных участков после смывания раствора в зависимости от степени деминерализации варьирует от бледно-голубого до темно-синего (рис. 2.12).
Данный метод удобен для дифференциальной диагностики начального кариеса с некариозными поражениями твердых тканей зуба (гипоплазией, флюорозом), при которых окрашивания не происходит. Он может также служить для контроля эффективности реминерализирующей терапии.
Для обнаружения начальных форм кариеса, вторичного кариеса вокруг пломб, вкладок пользуются методом трансиллюминации: ткани зуба просвечивают через световод направленным пучком света от галогеновой лампы. Для этой цели применяют
специальные облучатели. Пораженные участки при трансиллюминации выглядят более темными.

Рис. 2.12. Очаги деминерализации эмали, окрашенные 2% раствором метиленового синего
Кроме того, для диагностики кариеса исследуют ткани зуба в отраженном свете и используют люминесценцию их в ультрафиолетовом свете. В последнее время люминесценцию твердых тканей зубов определяют с помощью лазерных источников света.
Использование аппарата «KaVo DIAGNOdent»
Для раннего выявления начальных кариозных поражений, в том числе на труднодоступных для обзора поверхностях зубов, используют аппарат «KaVo DIAGNOdent».
Принцип работы. Лазерный диод генерирует импульсные световые волны красного спектра определенной длины (655 нм). Световые волны концентрируют с помощью фиброоптического элемента и подводят непосредственно к поверхности зуба в виде луча холодного света с помощью гибкого волоконно-оптического световода и наконечника со специальными насадками. Патологически измененные ткани зуба отражают световые волны другой длины, чем интактная эмаль. Длина отраженных волн анализируется электроникой аппарата. При обнаружении деминерализованных тканей зуба появляется звуковой сигнал. Аппарат реагирует даже на минимальное поражение эмали; точность диагностики составляет 90%. Интенсивность флюоресценции определяется числовыми значениями:
0-10 - интактная эмаль;
10-25 - деминерализация в пределах эмали;
25 и более - кариес дентина.
Методика. Поверхность зуба тщательно очищают от налета, изолируют от слюны, высушивают, затем наконечник аппарата с насадкой медленно продвигают вдоль исследуемого участка (насадку располагают перпендикулярно, в контакте с поверхностью зуба либо на расстоянии не более 1,5 мм) (рис. 2.13). Для большей точности проводят повторные измерения, определяя среднее значение.

Рис. 2.13. Диагностика начальных кариозных поражений с помощью «KaVo DIAGNOdent»
Важное значение имеет метод зондирования тканей зуба, при котором начальные стадии нарушения эмали определяются в виде участков с шероховатой поверхностью. По мере развития кариеса
с помощью этого метода можно оценить глубину поражения и выявить зоны болезненности.
Достаточно информативна термометрия, которая позволяет провести дифференциальную диагностику различных стадий кариеса и болезней пульпы зуба.
Определенное значение в диагностике кариеса зубов имеет электроодонтодиагностика (ЭОД). Этот метод позволяет определить состояние пульпы зуба. Здоровые зубы реагируют на токи от 2 до 6 мкА. При глубоком кариесе электровозбудимость тканей может снижаться до 10-15 мкА.
Для диагностики кариеса широко используют рентгенологический метод, дающий возможность выявить апроксимальные и поддесневые кариозные поражения, вторичный кариес под пломбами, а также определить глубину кариозной полости и ее взаимоотношение с полостью зуба.
Естественно, что наряду с этими важными методами первостепенное значение имеют основные методы исследования - опрос и осмотр.
2.10.2. КЛИНИЧЕСКАЯ КАРТИНА КАРИЕСА ЗУБОВ
2.10.2.1. КЛИНИЧЕСКАЯ КАРТИНА КАРИЕСА ЭМАЛИ В СТАДИИ БЕЛОГО (МЕЛОВИДНОГО) ПЯТНА
(НАЧАЛЬНОГО КАРИЕСА) (К02.0)
2.10.2.2. КЛИНИЧЕСКАЯ КАРТИНА КАРИЕСА ЭМАЛИ ПРИ НАЛИЧИИ ДЕФЕКТА В ЕЕ ПРЕДЕЛАХ (К02.0) (ПОВЕРХНОСТНОГО КАРИЕСА)
2.10.2.4. КЛИНИЧЕСКАЯ КАРТИНА НАЧАЛЬНОГО ПУЛЬПИТА (ГИПЕРЕМИИ ПУЛЬПЫ) (К04.00)
(ГЛУБОКОГО КАРИЕСА)
2.10.3. ДИФФЕРЕНЦИАЛЬНАЯ ДИАГНОСТИКА КАРИЕСА ЗУБОВ
2.10.3.1. ДИФФЕРЕНЦИАЛЬНАЯ ДИАГНОСТИКА КАРИЕСА ЭМАЛИ В СТАДИИ БЕЛОГО (МЕЛОВИДНОГО) ПЯТНА (НАЧАЛЬНОГО КАРИЕСА) (К02.0)
2.10.3.2. ДИФФЕРЕНЦИАЛЬНАЯ ДИАГНОСТИКА КАРИЕСА ЭМАЛИ ПРИ НАЛИЧИИ ДЕФЕКТА В ЕЕ ПРЕДЕЛАХ (К02.0) (ПОВЕРХНОСТНОГО КАРИЕСА)
2.10.3.3. ДИФФЕРЕНЦИАЛЬНАЯ ДИАГНОСТИКА КАРИЕСА ДЕНТИНА (К02.1) (СРЕДНЕГО КАРИЕСА)
2.10.3.4. ДИФФЕРЕНЦИАЛЬНАЯ ДИАГНОСТИКА НАЧАЛЬНОГО ПУЛЬПИТА (ГИПЕРЕМИИ ПУЛЬПЫ) (К04.00) (ГЛУБОКОГО КАРИЕСА)
2.10.4. КАРИЕС ЦЕМЕНТА (К02.2)
Наряду с коронковой частью может поражаться кариесом и корень зуба. Кариес корня в основном встречается у лиц старше 35-45 лет. При поражении корня могут развиться кариес цемента (К02.2), кариес дентина корня (К02.1), а при определенных условиях возможна приостановка кариеса (К02.3).
Обязательное условие развития кариеса корня - рецессия десны, в результате чего обнажается часть корня. Большое значение придается плохой гигиене полости рта. Важную роль играют возраст, избыток углеводов в диете, воспалительные заболевания пародонта.
Непосредственной причиной кариеса цемента являются органические кислоты, накапливающиеся в зубном налете в результате ферментативной деятельности кариесогенных микроорганизмов при избытке углеводов в диете и неудовлетворительной гигиене полости рта. Значение рН зубного налета ниже критического уровня приводит к деминерализации цемента или дентина корня зуба.
Визуально очаги поражения при кариесе цемента после высушивания поверхности корня выглядят как желтые пятна небольшого размера. Цемент имеет небольшую толщину, поэтому он быстро истирается с поверхности обнаженного участка корня в процессе жевания или гигиенических процедур. В результате этого кариес цемента очень быстро распространяется на дентин корня. Поражение кариесом дентина корня, как и цемента в начальных стадиях, сопровождается изменением его окраски в результате деминерализации. Течение кариеса корня часто хроническое. Очаг поражения в большей степени распространяется по поверхности корня и в меньшей степени в глубину. Обычно процесс имеет бессимптомное течение до тех пор, пока в него не вовлечена пульпа зуба. Больных в большей степени беспокоит косметический аспект.
Дифференциальную диагностику кариеса цемента и дентина корня необходимо проводить с кариесом пришеечной части коронки зуба, клиновидным дефектом, эрозией эмали.
Лечение кариеса цемента и кариеса дентина корня в начальных стадиях должно заключаться в назначении рациональных гигиенических процедур, проведении реминерализирующей терапии. В результате консервативного лечения при условии качественной гигиены полости рта пораженные участки постепенно пигментируются, приобретая различные оттенки коричневого цвета. Пораженная ткань становится плотной и блестящей. Кариозную полость необходимо пломбировать. Эффект пломбирования во многом зависит от тщательности соблюдения больным гигиенических рекомендаций. Важное значение имеет сбалансированность диеты в отношении углеводов.
Кариозные полости препарируют по V классу Блека. В качестве пломбировочных материалов можно использовать серебряную амальгаму, стеклоиономерные цементы и композитные материалы.
2.10.5. ПРИОСТАНОВИВШИЙСЯ КАРИЕС ЗУБОВ (К02.3)
В настоящее время доказано, что даже при активно текущем кариозном процессе одновременно с выраженной деминерализацией происходит реминерализация эмали. При определенных условиях и степени деминерализации эмали кариозный процесс может приостановиться. Обязательным условием для реминерализации является целостность органического матрикса эмали.
Из анамнеза можно выяснить, что очаги измененного цвета эмали существуют в течение длительного времени. Характер дефекта при поражении нескольких зубов одинаков. При обследовании обнаруживают шероховатость поверхности эмали в области пятна, но целостность поверхностного слоя не нарушена.
Многообразие цветовых оттенков кариозных пятен позволяет отнести белые кариозные пятна к быстропрогрессирующей деминерализации. Светло-коричневые пятна характерны для интермиттирующей деминерализации эмали, а темнокоричневый и черный цвета кариозных пятен свидетельствуют о приостановившемся процессе деминерализации. Наблюдаются переходные случаи, когда имеется сочетание белых участков деминерализации с различными оттенками пигментации в области одного пятна. Это может быть связано с неравномерностью процессов деминерализации и реминерализации в различных зонах кариозного пятна.
Предполагают, что кариес может приостановиться на любой стадии развития кариозного пятна, однако стабилизация или приостановка процесса деминерализации возможны только при переходе белого кариозного пятна в пигментированное. При белых и светло-коричневых пятнах патологический процесс имеет в основном интермиттирующий характер.
Появление пигментированного субстрата - признак перемежающегося процесса деминерализации, который зависит от интенсивности двух противоположных процессов - деминерализации и реминерализации и может вести к дезинтеграции или стабилизации патологического процесса, признаком чего в большинстве случаев является коричневый или черный цвет пятна.
Начало кислотного воздействия на эмаль не означает обязательного развития кариозного дефекта в ней. За счет буферных свойств слюны возможна реминерализация частично деминерали-
зованной эмали. Процессы деминерализации и реминерализиции зависят не только от местных факторов (углеводов, зубного налета, уровня гигиены полости рта, наличия фтора в питьевой воде), они тесно взаимосвязаны с общим состоянием организма (возрастом, болезнями и т.д.), а также с медикосоциальными факторами (образом жизни, образованием, доходами и др.). Общее состояние организма влияет на развитие кариеса опосредованно, через слюну, за счет изменения скорости секреции, ее количества и буферных свойств ротовой жидкости.
Важное значение в развитии приостановившегося кариеса играет сохранение наружного, в значительной степени интактного поверхностного слоя эмали, который, обладая свойствами ионноселективной мембраны, обеспечивает возможность не только развития подповерхностного очага деминерализации, но и реминерализации.
При белом кариозном пятне в случае устранения кариесогенной ситуации обратное развитие или приостановка деминерализации могут произойти самостоятельно за счет реминерализирующих свойств ротовой жидкости или в результате применения реминерализирующих препаратов.
При пигментированном кариозном пятне, которое является стабилизированной стадией кариеса, реминерализирующая терапия, как правило, не дает эффекта. Тактика стоматолога при наличии пигментированного пятна может заключаться в следующем. В тех случаях, когда кариозные пятна незначительны по площади или расположены в местах, доступных гигиеническим процедурам, возможно динамическое наблюдение за их состоянием. В остальных случаях, особенно при локализации пятен на контактных поверхностях, целесообразно иссечение измененных тканей с последующим пломбированием дефекта.
КЛИНИЧЕСКАЯ СИТУАЦИЯ 1
Пациентка 30 лет явилась на профилактический осмотр. При осмотре полости рта выявлено, что десна гиперемирована, отечна, кровоточит при зондировании. Зубы покрыты мягким налетом. После снятия налета на вестибулярной поверхности в пришеечной области зубов 13, 33, 32, 31, 41, 42 были обнаружены белые меловидные пятна, потеря естественного блеска эмали. Изменение цвета эмали соответствующих зубов ранее не выявлялось.
1. К каким поражениям относится данная патология?
2. Поставьте диагноз.
3. Какие дополнительные методы диагностики можно использовать?
4. Проведите дифференциальную диагностику заболеваний зубов.
5. Составьте план лечения данного заболевания.
КЛИНИЧЕСКАЯ СИТУАЦИЯ 2
Пациент явился на профилактический осмотр. При осмотре полости рта выявлено - десна бледнорозовая, умеренно увлажнена. На жевательных поверхностях зубов 35, 36, 47 имеются пигментированные фиссуры. Зондирование безболезненно, зонд задерживается в фиссуре.
1. Составьте план обследования.
2. Проведите дифференциальную диагностику заболеваний зубов.
3. Поставьте диагноз.
ДАЙТЕ ОТВЕТ
1. Критерии оценки кариозных поражений:
1) индексы гигиены полости рта;
2) индекс ПМА;
3) индексы кровоточивости тканей пародонта;
4) интенсивность кариеса зубов;
5) скорость секреции слюны.
2. Проницаемость эмали повышается при следующих заболеваниях:
1) флюорозе;
2) эрозии эмали;
3) кариесе в стадии белого кариозного пятна;
4) кариесе дентина;
5) генерализованном пародонтите средней степени тяжести.
3. Кривая Стефана отражает:
1) динамику изменения вязкости слюны при кариесе;
2) изменение скорости секреции слюны при кариесе;
3) гигиеническое состояние полости рта;
4) динамику изменения рН зубного налета под воздействием углеводов;
5) степень проницаемости эмали при кариесе зубов.
4. Витальное окрашивание твердых тканей зуба проводят:
1) в целях диагностики кариеса в стадии белого кариозного пятна;
2) для лечения кариеса в стадии белого кариозного пятна;
3) для диагностики кариеса дентина;
4) для определения гигиенического состояния полости рта;
5) в целях диагностики хронического периодонтита.
5. Для кариеса дентина характерны следующие жалобы:
1) ночные боли;
2) приступообразные боли;
3) кратковременные боли от химических раздражителей;
4) постоянные ноющие боли;
5) боли при перкуссии.
6. Согласно классификации МКБ-С-3 выделяют кариес:
1) средний;
2) глубокий;
3) кариес эмали;
4) поверхностный;
5) быстропрогрессирующий кариес.
7. Цветом кариозных пятен характеризуются:
1) длительность течения кариеса;
2) степень активности кариеса;
3) глубина поражения твердых тканей зуба;
4) степень вовлечения в процесс дентина;
5) переход кариеса эмали в кариес дентина.
8. Полость при кариесе дентина расположена в пределах:
1) пульпы зуба;
2) дентина;
3) эмали и дентина;
4) эмали;
5) периодонта.
9. При кариесе дентина зондирование полости:
1) болезненно во всех зонах;
2) болезненно в области дна полости;
3) безболезненно во всех зонах;
4) болезненно в одной точке;
5) болезненно в области эмалево-дентинного соединения.
10. Для определения интенсивности кариеса используют:
1) индекс зубного налета по Федорову-Володкиной;
2) оценку распространенности кариеса;
3) индекс РМА;
4) индекс КПУ;
5) индекс CPITN.
ПРАВИЛЬНЫЕ ОТВЕТЫ
1 - 4; 2 - 3; 3 - 4; 4 - 1; 5 - 3; 6 - 3; 7 - 2; 8 - 3; 9 - 5; 10 - 4.